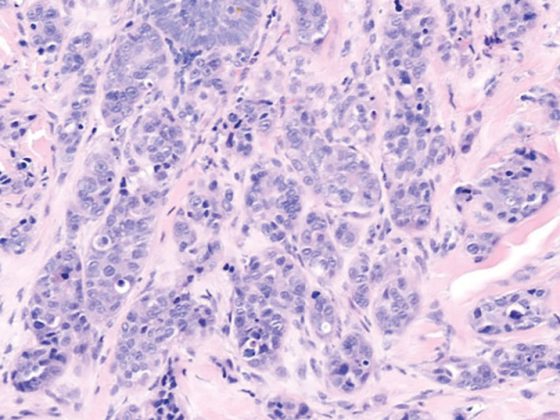
sacuman_dpheader

Wenn Kaliumüberschuss schwerwiegend wird, kann es zu lebensbedrohlichen Herzrhythmusstörungen kommen. Insbesondere Niereninsuffizienz, Herzinsuffizienz und Diabetes sowie gewisse Medikamente begünstigen das Entstehen einer Hyperkaliämie. Die Behandlung mit oralen Kaliumbindern ermöglicht eine Senkung der Kaliumspiegel parallel zur Fortführung zentraler Therapien wie beispielsweise mit RAAS-Inhibitoren oder Aldosteronantagonisten. Neben dem vor einigen Jahren zugelassenen Patiromer steht in der Schweiz mit Natriumzirconiumcyclosilicat seit 2021 eine weitere Therapieoption zur Verfügung.